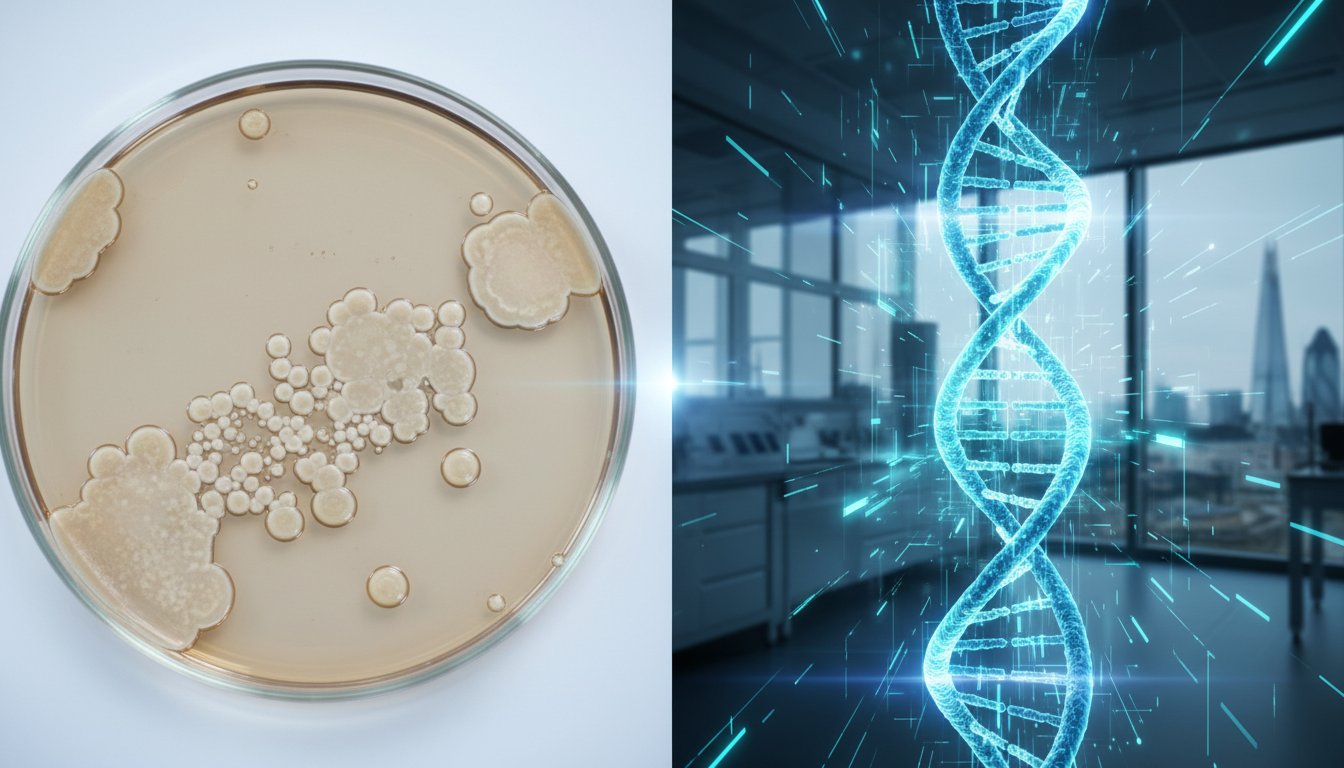
MRSA Culture vs. PCR Test Accuracy: Which Screening Method Is Best in 2026?

MRSA Culture vs. PCR Test Accuracy: Which Screening Method Is Best in 2026?
The most thorough medical test isn’t always the right choice when you’re racing against a strict hospital deadline. You’ve likely spent weeks preparing for a surgery date, only to find that a missing screening result could postpone your entire recovery plan. It’s natural to feel overwhelmed by medical jargon or the pressure of providing documentation to your consultant on time. You want to ensure you’re safe and clear of infection, but you also need a process that’s simple, professional, and discreet.
This clinical comparison breaks down mrsa culture vs pcr test accuracy to help you choose the right balance of speed and precision for your needs in 2026. We’ll explain why a PCR rapid test provides molecular detection in as little as 24 hours, while traditional culture methods may require up to 72 hours to confirm colonization. By the end of this guide, you’ll have the confidence to select a UKAS-accredited testing method that meets hospital requirements and provides the fast results you need for total peace of mind.
Key Takeaways
- Understand the clinical differences between traditional lab cultures and rapid molecular detection to ensure you meet specific UK hospital pre-admission requirements.
- Evaluate the trade-offs between sensitivity and specificity by comparing mrsa culture vs pcr test accuracy to choose the right level of precision for your clinical needs.
- Discover how to balance the “time-to-result” factor, determining when the speed of a PCR test is essential for meeting urgent pre-operative timelines.
- Learn how to obtain hospital-grade results through discreet self-collection kits processed by trusted, UKAS-accredited partner laboratories across the UK.
Understanding MRSA Screening: Culture vs. PCR Methods
Methicillin-resistant Staphylococcus aureus (MRSA) is a strain of bacteria that has developed resistance to common antibiotics like methicillin and penicillin. In the UK, screening has been a standard safety protocol for many NHS and private hospitals since 2008. This mandatory process ensures that patients carrying the bacteria are identified before surgery to prevent serious post-operative infections. When you are preparing for a procedure, understanding mrsa culture vs pcr test accuracy helps you choose the right screening option for your timeline.
The culture method relies on growing live bacteria in a laboratory. It’s the traditional approach that clinical teams have used for decades. In contrast, the PCR (Polymerase Chain Reaction) method is a modern molecular technique that detects bacterial DNA directly from your sample. The fundamental difference lies in what the lab is looking for. A culture test confirms a living colony is present, while a PCR test identifies the genetic blueprint of the bacteria, even if the organism isn’t actively growing at that moment.
What is an MRSA Culture Test?
The culture process begins when your swabs arrive at a UKAS-accredited facility. Lab technicians place the samples onto chromogenic agar plates, which are special Petri dishes designed to change colour if MRSA is present. This method usually takes 48 to 72 hours because the bacteria must physically multiply until they’re visible to the human eye. To improve the yield and ensure no low-level colonization is missed, labs often use enrichment broths. These nutrient-rich liquids encourage even small amounts of bacteria to grow, though this adds time to the final result. It’s a slow but highly reliable way to confirm an active colonization.
What is an MRSA PCR Rapid Test?
Molecular detection via PCR is the fastest way to get answers. This science involves DNA amplification, where the lab targets and copies specific segments of genetic material millions of times. A key focus is the mecA gene, which is the specific genetic marker responsible for methicillin resistance. Because the lab doesn’t need to wait for bacteria to grow, a PCR rapid test can provide results in as little as 24 hours. This speed is vital for patients with tight surgical deadlines. When considering mrsa culture vs pcr test accuracy, PCR is often praised for its high sensitivity, meaning it’s excellent at ruling out the presence of the bacteria quickly and safely from the comfort of your own home.
Comparing the Accuracy: Sensitivity and Specificity Explained
Understanding mrsa culture vs pcr test accuracy requires a look at two clinical metrics: sensitivity and specificity. Sensitivity refers to a test’s ability to correctly identify individuals who truly have MRSA. A high sensitivity rate means there are very few “false negatives,” ensuring that colonised individuals aren’t missed. Specificity measures the test’s ability to correctly identify those without the bacteria. High specificity prevents “false positives,” which can lead to unnecessary isolation or treatment in UK hospitals.
A 2026 clinical meta-analysis suggests that while both methods are highly reliable, they serve different clinical purposes. A test might be exceptionally accurate at finding the smallest trace of DNA but limited because it cannot distinguish between living bacteria and harmless fragments. This distinction is vital for patients seeking a clear, clinical picture of their health status. For those who value certainty, using a professional MRSA home test kit ensures the process is handled by a UKAS-accredited laboratory.
PCR Accuracy: High Sensitivity, Rapid Detection
PCR testing is renowned for its speed and its ability to detect MRSA at very low levels. Clinical data shows that PCR sensitivity often exceeds 92%, making it a powerful tool for rapid screening. Because it looks for genetic markers rather than waiting for bacteria to grow, it provides results in a fraction of the time required by traditional methods.
The primary limitation of PCR is the risk of false positives. According to a meta-analysis on diagnostic accuracy, PCR can detect non-viable or “dead” DNA from bacteria that are no longer active. This means a patient might test positive even if they aren’t currently infectious. Despite this, PCR remains the preferred “rule-out” method for emergency admissions in the UK because a negative result is almost 100% certain.
Culture Accuracy: The Gold Standard for Specificity
The culture test remains the gold standard for specificity, often reaching 99% accuracy in identifying live, colonised MRSA. Unlike PCR, a culture only yields a positive result if the bacteria are alive and capable of replicating. This confirms an active colonisation rather than just the presence of genetic debris.
However, culture tests face a “sensitivity gap.” If a patient has very low-level colonisation, the sample might not contain enough bacteria to grow on the agar plate within the first 24 hours. Clinical guidelines emphasise the importance of the 48-hour mark for maximising culture accuracy. Waiting for this full incubation period ensures that even slow-growing strains are identified, providing a definitive answer for patients and healthcare providers alike.

Speed vs. Precision: When Timing Dictates the Test Choice
When evaluating mrsa culture vs pcr test accuracy, the primary concern for most patients is how quickly they can safely proceed with their medical treatment. The choice between these two methods often depends on your specific surgical timeline. If your hospital admission or pre-operative assessment is less than 72 hours away, the need for speed usually dictates the testing route. PCR tests identify the genetic material of the Staphylococcus aureus bacteria almost immediately, allowing for rapid clinical decisions.
The clinical trade-off isn’t a matter of one test being “better” than the other; rather, they provide different types of data. A faster result isn’t less reliable in terms of detection, but it offers less information about the specific strain’s behavior. To ensure the highest standards, all samples processed through mrsatest.co.uk are handled by UKAS-accredited laboratories. This accreditation confirms that the facility meets rigorous ISO standards for technical competence and quality control, ensuring that your results are trustworthy regardless of the method chosen.
Logistics play a significant role in at-home testing within the UK. While the lab work itself is fast, you must account for transit times. We use tracked courier services to ensure swabs reach the lab within 24 hours of posting. Once the sample is logged at our facility, the diagnostic process begins immediately. This streamlined system reduces the anxiety associated with waiting for clear clearance before a major procedure.
- PCR: Best for urgent timelines (results typically within 24 hours of lab receipt).
- Culture: Best for routine screening (results typically within 48 to 72 hours of lab receipt).
- Quality: Both methods utilize UKAS-accredited processes for maximum safety.
The 24-Hour Advantage of PCR
You should choose a PCR test if you have a surgery date or hospital admission scheduled within the next three days. Because this method detects DNA, it provides a definitive result shortly after the sample arrives at the laboratory. This rapid detection is vital for immediate infection control, as it allows you to start decolonization treatment right away if necessary. You can get fast, accurate results at home with a rapid PCR kit to meet these tight clinical deadlines without stress.
The 72-Hour Depth of Culture
While the mrsa culture vs pcr test accuracy comparison shows both methods are highly reliable, the culture test is the standard for routine screenings where time isn’t the primary constraint. It takes longer because the lab must physically grow the bacteria in a controlled environment. This process is essential if a patient needs a specific treatment plan, as it allows scientists to see which antibiotics effectively kill the specific strain found. Understanding these nuances is a key part of managing hospital-acquired infections (HAIs) and understanding patient risks before entering a clinical setting.
Clinical vs. Home Use: Which Test Meets Your Requirements?
Choosing between a hospital-led screening and a private home kit depends on your specific clinical needs and the timeline set by your surgical team. Most surgeons require proof of a negative MRSA status before admitting you to the operating theatre to prevent post-operative infections. You should check if your hospital specifies a testing method, as some private clinics strictly require a PCR result for last-minute admissions. While hospital staff are trained in collection, a home kit provides a discreet, stress-free alternative that avoids an extra trip to a clinical setting.
The mrsa culture vs pcr test accuracy remains high for both methods when samples are collected correctly. However, self-collection introduces a variable that professional swabbing avoids. if you don’t apply enough pressure or miss the key colonisation sites, the lab may return an “Inconclusive” result. This happens in approximately 2% to 5% of home tests, usually due to insufficient biological material on the swab. Weighing the price of a PCR test against the urgency of your procedure is vital; paying for a faster result is often cheaper than the £500 or more you might face in hospital cancellation fees.
Matching the Test to Your Surgery Timeline
Timing is the most critical factor in your decision. If your surgery is scheduled for more than 7 days away, the MRSA Culture test is the gold standard for cost-effectiveness. It’s highly specific but requires 2 to 3 days for the laboratory to incubate the sample. For those with surgery in less than 4 days, the PCR test is the only viable choice. It identifies MRSA DNA within 24 hours of reaching the lab, ensuring you have your certificate in time. You can find more details in our Preparing for Surgery: A Complete Pre-Op Health & Logistics Checklist.
Swabbing Technique: Maximizing Your Test’s Accuracy
To ensure the mrsa culture vs pcr test accuracy is not compromised, you must follow the “Nose, Groin, Axilla” triad. MRSA often colonises multiple areas of the body, and swabbing only one site can lead to a false negative. Follow these steps for a valid sample:
- Nose: Insert the swab into the front of each nostril and rotate firmly 5 times.
- Axilla: Rub the swab across the skin of both armpits.
- Groin: Swab the skin folds on both sides of the groin area.
Once collected, place the swab immediately into the transport tube. Don’t leave the sample in direct sunlight or near a heat source. Store it at room temperature and use the pre-paid, discreet packaging to return it to our UKAS-accredited lab the same day. This efficiency prevents sample degradation and ensures your results are processed without delay. Taking these steps ensures your home sample is just as reliable as one taken in a GP surgery.
Take control of your pre-operative requirements and order your discreet MRSA home test kit for professional results from the comfort of your home.
Reliable At-Home MRSA Testing with mrsatest.co.uk
Understanding the technical nuances of mrsa culture vs pcr test accuracy is the first step toward taking control of your health. However, clinical knowledge is only effective when paired with accessible, high-quality diagnostics. At mrsatest.co.uk, we bridge the gap between complex laboratory science and the privacy of your own home. We provide a service that prioritises clinical excellence without the need for a stressful clinic visit or long waiting times.
Our 100% UK-based processing ensures that your samples don’t travel across borders, reducing the risk of degradation and speeding up your results. By combining the precision of professional medical screening with the convenience of a home kit, we offer a solution that is both dependable and discreet. Whether you are screening before a planned surgery or checking for peace of mind, our process is designed to be simple and supportive.
Why Choose Our Accredited Lab Testing?
The cornerstone of our service is our partnership with UKAS-accredited laboratories. UKAS accreditation is the gold standard for medical testing in the United Kingdom, signifying that a lab meets rigorous ISO standards for competence and consistency. This accreditation is vital because it guarantees that the debate over mrsa culture vs pcr test accuracy is handled by experts using calibrated equipment and validated methods.
Trust is built on security as much as science. We adhere strictly to GDPR regulations to ensure your personal and medical data remains protected at every stage. Your results are never shared with third parties, including your GP, unless you choose to do so yourself. If you’re still learning about the risks associated with this bacteria, you can read more in our guide: What Is MRSA? Your Complete Guide to Symptoms, Causes & Risks.
Ordering Your PCR or Culture Kit Today
We’ve streamlined the testing process into three manageable steps to reduce anxiety and ensure a high-quality sample collection. Your kit arrives in plain packaging with no mention of MRSA or testing on the outside, maintaining your total privacy.
- Order: Select the PCR or Culture test on our website. Your kit is dispatched quickly via first-class post.
- Swab: Follow the clear, illustrated instructions to collect your samples from the comfort of your home. The kit includes everything you need: sterile swabs, transport tubes, and a return bag.
- Post: Use the pre-paid envelope to send your samples directly to our UK laboratory.
Once our lab completes the analysis, you’ll receive your results via a secure, password-protected email. This ensures you can review your status privately and decide on your next steps with confidence. Don’t leave your health to chance. Order your confidential MRSA test kit now and get the professional answers you need without the wait.
Securing Your Health with Modern MRSA Screening
Deciding on the right screening method involves weighing the 24 hour speed of molecular detection against the detailed 48 to 72 hour profile provided by traditional growth cultures. Both methods offer high reliability, but your choice often hinges on how quickly you need answers before a hospital admission or after completing a treatment cycle. Understanding mrsa culture vs pcr test accuracy is vital for making an informed decision about your personal healthcare journey in 2026. While PCR is excellent for rapid clearance, culture tests remain the gold standard for identifying specific antibiotic sensitivities.
You don’t have to navigate these medical choices alone or wait in a crowded clinic. Our service connects you directly with UKAS-accredited partner laboratories to ensure your results meet the highest clinical standards. Everything we do is 100% UK-based, providing you with local expertise and reliable support throughout the process. We prioritize your privacy by using plain, discreet packaging for every order, ensuring your health remains your personal business. It’s a simple, professional way to gain peace of mind from the comfort of your own home. Take the first step toward certainty today.
Order Your Professional MRSA Home Test Kit Today
Frequently Asked Questions
Is a PCR test more accurate than a culture test for MRSA?
PCR tests generally offer higher sensitivity, often exceeding 95% in clinical studies published in the Journal of Clinical Microbiology. This means they’re excellent at detecting even small amounts of the bacteria’s DNA. While culture tests are the traditional gold standard, they rely on bacterial growth which can sometimes fail. When comparing mrsa culture vs pcr test accuracy, PCR provides a faster, highly reliable molecular detection method for your peace of mind.
Can a PCR test give a false positive for MRSA?
Yes, a PCR test can occasionally yield a false positive because it detects DNA fragments rather than live bacteria. The test might identify MRSA genetic material from dead organisms or successful past treatments. Clinical data indicates false positive rates for rapid PCR screening are typically below 5%. It’s a highly sensitive tool, but doctors often use it alongside your clinical history to ensure the most accurate diagnosis for your health.
How long does it take to get MRSA culture results compared to PCR?
MRSA culture results typically take 48 to 72 hours because the laboratory must wait for the bacteria to grow in a controlled environment. In contrast, a PCR rapid test can provide results in as little as 24 hours after reaching our UKAS-accredited facility. This speed makes PCR the preferred choice for urgent screenings. You’ll receive your confidential results via a secure portal, allowing you to take action without any unnecessary delay.
Will my hospital accept an at-home MRSA test result?
Most UK hospitals accept results from UKAS-accredited laboratories, but you should always verify this with your specific surgical team first. Our kits use the same professional swabs and clinical standards found in NHS settings. Since many elective surgeries require proof of a negative result within 14 days of the procedure, providing a certified report from a trusted UK partner laboratory helps streamline your pre-admission process from the comfort of your own home.
Which test should I choose if I am screening for surgery next week?
If your surgery is scheduled for next week, the PCR test is the most efficient option due to its rapid turnaround time. Because it offers high mrsa culture vs pcr test accuracy by detecting DNA, it provides the quick clearance many surgeons require. Getting your results within 24 hours of the lab receiving your sample ensures you meet tight pre-operative deadlines. It’s a simple, discreet way to ensure your procedure remains on schedule.
Does a negative MRSA culture test mean I am definitely not colonised?
A negative culture test is highly reliable, but it doesn’t offer a 100% guarantee because bacterial shedding can be intermittent. If the bacterial load is very low on the day of your swab, the culture might not show growth. Studies show culture tests have a sensitivity range between 70% and 90%. If you have a high risk of exposure, a follow-up test or a more sensitive PCR screening can provide additional clinical certainty.
What happens if my MRSA test result is positive?
If your result is positive, it means MRSA was detected on your skin or in your nose, a state known as colonisation. You’ll likely need a decolonisation treatment, which usually involves a five-day course of special antibacterial body wash and nasal cream. Don’t worry, as being colonised isn’t the same as having an active infection. Your GP or hospital team will guide you through the simple steps to clear the bacteria before any planned procedures.
Why is the PCR test more expensive than the culture test?
The higher cost of the PCR test reflects the advanced molecular technology and specialized laboratory equipment required to isolate bacterial DNA. While culture tests involve traditional incubation on agar plates, PCR uses complex reagents to provide a result in a fraction of the time. You’re paying for the speed of a 24-hour turnaround and the increased sensitivity of the detection method. This investment provides faster answers and greater convenience for your schedule.